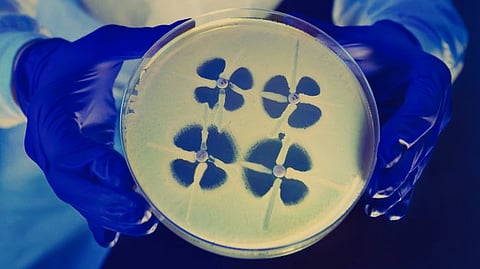
The new study led by RMIT University and the University of South Australia (UniSA) tested black phosphorus-based nanotechnology as an advanced infection treatment and wound healing therapeutic.(Representational Image: CDC PHIL)

Researchers have invented a nano-thin superbug-slaying material that could one day be integrated into wound dressings and implants to prevent or heal bacterial infections.
Antibiotic resistance is a major global health threat, causing about 700,000 deaths annually, a figure which could rise to 10 million deaths a year by 2050 without the development of new antibacterial therapies.
The new study led by RMIT University and the University of South Australia (UniSA) tested black phosphorus-based nanotechnology as an advanced infection treatment and wound healing therapeutic.
The treatment achieved comparable results to an antibiotic in eliminating infection and accelerated healing, with wounds closing by 80% over seven days.
The superbug-killing nanotechnology developed internationally by RMIT was rigorously tested in pre-clinical trials by wound-healing experts at UniSA. RMIT has sought patent protection for the black phosphorus flakes including its use in wound healing formulations, including gels.
RMIT co-lead researcher,Professor Sumeet Walia, said the study showed how their innovation provided rapid antimicrobial action, then self-decomposed after the threat of infection had been eliminated.
The beauty of our innovation is that it is not simply a coating – it can actually be integrated into common materials that devices are made of, as well as plastic and gels, to make them antimicrobial.said Walia from
Professor Sumeet Walia,RMIT’s School of Engineering, co-lead researcher
A previous study led by RMIT revealed that black phosphorus was effective at killing microbes when spread in nano-thin layers on surfaces used to make wound dressings and implants such as cotton and titanium, or integrated into plastics used in medical instruments.
How the invention works
Black phosphorus is the most stable form of phosphorus - a mineral that is naturally present in many foods - and, in an ultra-thin form, degrades easily with oxygen, making it ideal for killing microbes.
The new study tested the effectiveness of nano-thin flakes of black phosphorus against five common bacteria strains, including E. coli and drug-resistant golden staph.
“Our antimicrobial nanotechnology rapidly destroyed more than 99% of bacterial cells – significantly more than common treatments used to treat infections today.”
The global war on superbugs
Co-lead researcher Dr Aaron Elbourne from RMIT said healthcare professionals around the world were in desperate need of new treatments to overcome the problem of antibiotic resistance.
Superbugs – the pathogens that are resistant to antibiotics – are responsible for massive health burdens and as drug resistance grows, our ability to treat these infections becomes increasingly challenging.If we can make our invention a commercial reality in the clinical setting, these superbugs globally wouldn’t know what hit them.
Elbourne, a Senior Research Fellow in RMIT’s School of Science
Treatment efficacy in preclinical models of wound infection
Lead researcher from UniSA, Dr Zlatko Kopecki, and his team performed the pre-clinical trials to show how daily topical application of the black phosphorus nanoflakes significantly reduced infection.
This is exciting as the treatment was comparable to the ciprofloxacin antibiotic in eradicating wound infection and resulted in accelerated healing, with wounds closing by 80% over seven days
Dr Zlatko Kopecki, Lead researcher from UniSA, Channel 7 Children’s Research Foundation Fellow in Childhood Wound Infections
Dr Kopecki, who is also a Channel 7 Children’s Research Foundation Fellow in Childhood Wound Infections, said antibiotic treatments are becoming scarce.
“We urgently need to develop new alternative non-antibiotic approaches to treat and manage wound infection,” he said.
The team wants to collaborate with potential industry partners to develop and prototype the technology.
‘Layered Black Phosphorus Nanoflakes Reduce Bacterial Burden and Enhance Healing of Murine Infected Wounds’ is published in ACS Applied Materials & Interfaces (DOI: 10.1002/adtp.202300235).
Emmeline P. Virgo, Hanif Haidari, Z. L. Shaw, Louisa Z. Y. Huang, Tahlia L. Kennewell, Luke Smith, Taimur Ahmed, Saffron J. Bryant, Gordon S. Howarth, Sumeet Walia, Allison J. Cowin, Aaron Elbourne and Zlatko Kopecki are co-authors.
(SC/Newswise)